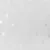

Панель декоративная DM629 W14 HIWOOD

При покупке обоев от:
- 30000 руб. - 3%
- 50000 руб. - 5%
- 70000 руб. - 7%
- 100000 руб. - 10%
Подробности уточняйте у менеджеров
Купить Панель декоративная DM629 W14 HIWOOD не составит никакого труда. Обратитесь к консультантам при оформлении заказа и они помогут рассчитать необходимое количество.
Отзывы не найдены